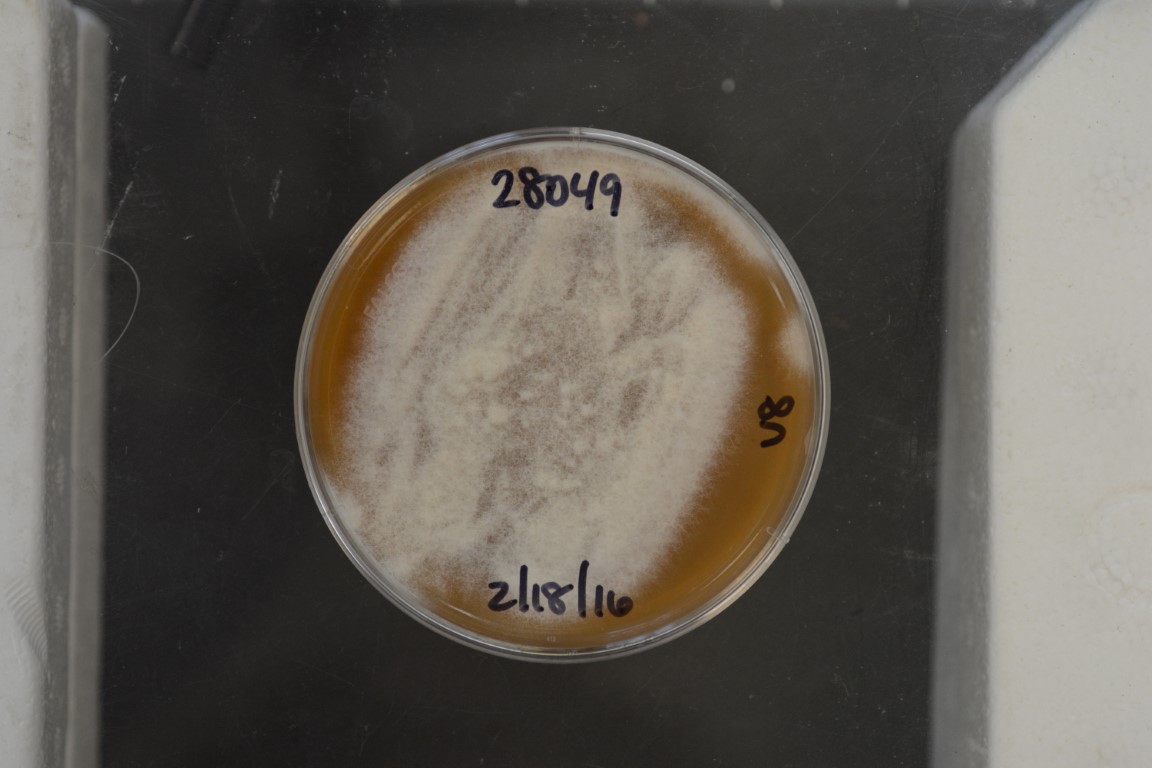

Fusarium cf.verticillioides
NRRL 28049
Accession numbers in other collections:M-2552
Source:Pennsylvania State University
Isolated from(substrate):Corn,Sweetina and Funk's
Substrate location:Purdue University,Indiana,USA
Growth media:Half-strength V8 Juice Agar(1/2 V8)(number 40)
Optimum growth temperature:25C
Strain images:
NRRL_28049_17.jpg

This strain is a regulated plant pathogen.An APHIS PPQ 526 permit is required for distribution in the United States.For international requests,an importation permit or an official letter from the appropriate government agency declaring that a permit is not required must be provided in advance of shipment.
NRRL28049